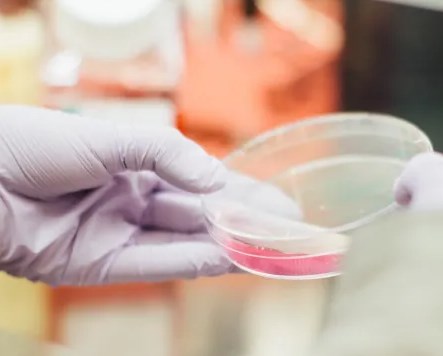
Thuốc giúp các tế bào thần kinh cảm giác phát triển lại

Lơ là kiểm soát đường huyết - Hậu quả khôn lường!
Đái tháo đường (hay còn gọi là bệnh tiểu đường) là một bệnh lý mạn tính biểu hiện bằng lượng đường trong máu tăng cao. Bệnh xảy ra khi tuyến tụy không sản xuất đủ hóc môn kiểm soát nồng độ đường huyết...